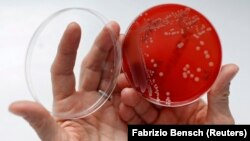
Seorang petugas laboratorium di Berlin, Jerman menunjukkan "superbug" atau bakteri kebal obat (foto: ilustrasi).

Organisasi Kesehatan Dunia (WHO) Jumat lalu memperingatkan, ketiadaan antibiotik baru sangat mengancam upaya mengekang penyebaran bakteri yang kebal obat, yang membunuh puluhan ribu orang setiap tahun.
Badan kesehatan PBB, WHO, menerbitkan dua laporan baru yang mengungkap, tidak banyak antibiotik baru yang ampuh dan siap diproduksi. Itu artinya, dunia kehabisan pilihan untuk memerangi apa yang disebut superbug, bakteri yang kebal obat.
"Belum pernah ada ancaman kekebalan antimikroba dan perlunya solusi, yang lebih mendesak seperti sekarang," ujar ketua WHO Tedros Adhanom Ghebreyesus dalam pernyataan.
"Sejumlah inisiatif dilakukan untuk mengurangi kekebalan, tetapi kami juga membutuhkan bantuan negara dan industri farmasi untuk terus menyediakan dana dan obat-obat baru yang inovatif," katanya.
Kekebalan antibiotik terjadi ketika bakteri menjadi kebal obat yang ada, sehingga cedera ringan, dan infeksi yang umum pun berpotensi mematikan.
Diperkirakan 33 ribu orang meninggal di Eropa setiap tahun akibat bakteri yang kebal obat, menurut data Uni Eropa. Di Amerika, jumlah kematian itu diperkirakan sekitar 35 ribu.
"Kami menyaksikan penularan ini dan kami kehabisan antibiotik yang ampuh melawan bakteri yang kebal ini," ujar Peter Beyer, dari divisi obat esensial WHO, kepada wartawan di Jenewa.
Ditemukan pada tahun 1920an, antibiotik telah menyelamatkan puluhan juta nyawa dengan mengalahkan penyakit akibat bakteri seperti pneumonia, TBC dan meningitis.
Tetapi selama berpuluh-puluh tahun, bakteri belajar melawan, membangun kekebalan terhadap obat yang dulu mengalahkan mereka - berubah menjadi apa yang disebut "superbug".
Untuk mencegah bakteri menjadi kebal obat yang biasa digunakan, perlu ada antibiotik baru, tetapi bagi perusahaan farmasi, membuat produk baru yang kompetitif adalah rumit, mahal, dan tidak dianggap sangat menguntungkan.
Menurut WHO, ke 60 produk baru yang saat ini sedang dibuat - 50 antibiotik dan 10 biologik - "menghadirkan sedikit manfaat dibandingkan obat yang ada dan hanya dua yang menarget bakteri yang kebal dan paling kritis," yang disebut bakteri Gram-negatif.
Sejumlah obat lain yang masih dalam pengujian pra-klinis, lebih inovatif, kata WHO, tetapi perlu bertahun-tahun sebelum obat itu dipasarkan.
Dari 252 obat semacam itu yang masih dalam tahap pengujian sangat awal, dua hingga lima produk pertama bisa tersedia dalam waktu sekitar 10 tahun, menurut skenario optimistis, kata WHO.
"Sangat penting untuk memfokuskan investasi publik dan swasta pada pembuatan obat yang ampuh melawan bakteri yang sangat kebal itu," ujar Hanan Balkhy, Asisten Direktur Jenderal WHO untuk Kekebalan Antimikroba, dalam pernyataan itu. "Kita tidak punya banyak pilihan,” katanya."(ka/ii)